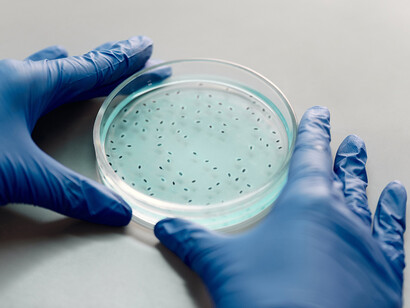
Bactéries. Les bactéries sont des êtres microscopiques ayant fait leur apparition sur le devant de la scène scientifico-médiatique à partir du milieu du XIXe siècle
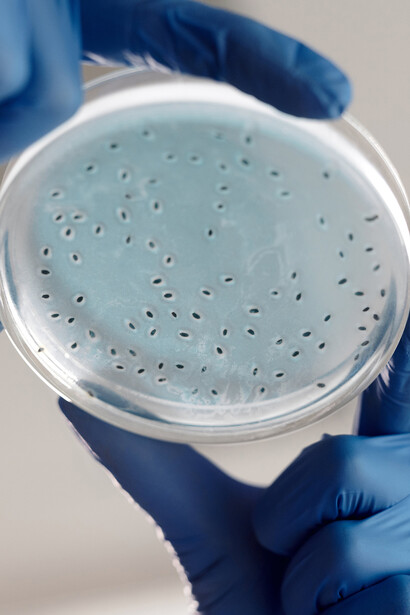
Bactéries. La β-G-ase n’est pas présente dans la cellule bactérienne tant qu’on ne l’a pas nourrie de lactose

Ayant rejoint le service d’André Lwoff à l’Institut Pasteur en 1945 après l’obtention de sa thèse de doctorat, Jacques Monod va délaisser les infusoires Ciliés – animaux unicellulaires microscopiques – pour le matériel de son patron : les bactéries, et en particulier la célèbre Escherichia coli, hôte de nos intestins. Inoffensive le plus souvent, elle contribue à la digestion de nos aliments, mais quelques souches peuvent s’avérer pathogènes et dangereuses. Comment le métabolisme de cette bactérie, objet des recherches initiales de Monod, conduira-t-il l’équipe du laboratoire au prix Nobel ? L’histoire est longue, riche en rebondissements, et se situe dans un contexte marqué autant par les controverses scientifiques que par les polémiques philosophico-politiques. Patience : de nombreux épisodes vont être nécessaires pour faire l’autopsie de cette découverte majeure.
Petite carte d’identité de la bactérie
Les bactéries sont des êtres microscopiques ayant fait leur apparition sur le devant de la scène scientifico-médiatique à partir du milieu du XIXe siècle. On doit notamment à notre célèbre Pasteur d’avoir contribué à montrer leur intervention dans un grand nombre de maladies infectieuses. Apparues très tôt dans l’histoire du vivant sur Terre, vers un peu moins de 4 milliards d’années selon les datations les plus récentes, elles se présentent comme des cellules isolées dotées d’un chromosome libre dans le cytoplasme, d’où leur qualificatif de procaryotes, par opposition aux cellules eucaryotes (pourvues d’un noyau qui emballe le stock de chromosomes) comme le sont celles de notre propre corps et de tous les animaux et végétaux.
Escherichia coli (en abrégé E. coli) mesure à peine 2 µm (micromètre) de long et ne pèse pas plus de 5. 10-13 gramme ! Elle se reproduit à une vitesse phénoménale, tant qu’elle trouve assez de nourriture. On peut aisément isoler et cultiver de nombreux mutants. Autant dire que c’est un matériel de choix pour le chercheur qui s’intéresse à la biométrie de ces cultures bactériennes. Monod, biochimiste devenu microbiologiste, passe alors une grande partie de son temps à établir les courbes de croissance de ses colonies bactériennes en fonction des sources de sucre dont il les nourrit. Il est alors frappé par un étrange phénomène, sur lequel nous reviendrons car il semble avoir été un déclencheur important dans sa réflexion, quoique la maturation fut assez lente, pour des raisons que nous tâcherons aussi d’élucider.
D’énigmatiques courbes de croissance
En nourrissant les colonies bactériennes avec deux sucres au lieu d’un seul, Monod obtient curieusement, selon le couple de sucres utilisé :
- Tantôt une courbe de croissance classique en forme de S très étiré,
- Tantôt une courbe de croissance qui présente, au milieu de la phase la plus rapide de la croissance, un palier qui marque l’arrêt momentané de la croissance avant sa reprise (voir figure 1).
 Fig.1 Courbes de croissance de E. coli . En bas (d, e, f), diauxie marquée. Source : Wikipédia.
Fig.1 Courbes de croissance de E. coli . En bas (d, e, f), diauxie marquée. Source : Wikipédia.
Il baptise ce phénomène la diauxie (croissance double, ou à deux phases), sans en avoir encore aucun début d’explication.
Pour grandir et se multiplier, il faut se nourrir
Parmi les sucres habituellement consommés par E. coli figure le lactose (sucre du lait). C’est un sucre dit en C12 (12 atomes de carbone), qui associe par liaison chimique deux sucres plus simples, le galactose et le fructose dits en C6, à 6 atomes de carbone (voir figure 2).
Or le lactose, parce qu’il est un sucre composé, doit au préalable être scindé en ses deux sucres simples constitutifs pour qu’ensuite la cellule puisse oxyder complètement ces derniers et récupérer l’énergie nécessaire à sa vie, selon le célèbre bilan chimique de la respiration :
C6 H12 O6 + 6 O2 -------> 6 H2O + 6 CO2 + énergie
Mais comment s’opère la cassure préalable de la molécule de lactose ? Chimiquement parlant, il s’agit d’une hydrolyse : cassure par action de l’eau. Pourtant cette réaction chimique, comme l’a montré la biochimie connue de Monod, ne s’effectue pas simplement et directement dans la cellule, et surtout pas suffisamment rapidement pour ses besoins nutritifs. Comme la plupart des milliers de réactions chimiques cellulaires, elle est accélérée grâce à un catalyseur présent dans la cellule. Les catalyseurs biologiques sont nommés enzymes et celles-ci ont été identifiées comme des protéines. L’hydrolyse du lactose, réaction réversible, est catalysée et de fait rendue possible en pratique par une enzyme appelée bêta-galactosidase, notée en abrégé β-G-ase (voir figure 3).
 Fig. 3 Hydrolyse du lactose grâce à la bêta-galactosidase. La version hydrolyse est ici schématisée de droite à gauche.
Fig. 3 Hydrolyse du lactose grâce à la bêta-galactosidase. La version hydrolyse est ici schématisée de droite à gauche.
La bêta-galactosidase devient à partir de ce moment la molécule fétiche de Jacques Monod. Mais quel rapport avec l’expression des gènes, qui mènera au prix Nobel ?
La bêta-galactosidase
Si la génétique – discipline qui étudie les gènes et la transmission des caractères entre les générations – est reconnue à partir du début du XXe siècle grâce à la redécouverte des travaux du moine Mendel au siècle précédent sur la transmission des caractères chez le petit pois, la biochimie domine en cette fin de XIXe siècle. Elle se consacre à l’élucidation de la structure chimique et des fonctions des constituants fondamentaux de la matière vivante, et à l’étude du métabolisme. On connaissait assez bien depuis la fin du XVIIIe siècle la famille des glucides (sucres au sens large) et celle des lipides (graisses). On savait l’existence d’une autre famille, caractérisée par la présence d’azote, nommée alors matière albumineuse par le chimiste Fourcroy, collègue de Lavoisier. On ignorait tout de sa structure chimique et de son rôle. De ce fait, les protéines occupent encore le devant de la scène au milieu du XXe siècle, surtout en France, où les travaux du généticien américain Morgan sont peu connus.
Une protéine est un filament formé par l’enchaînement en « collier de perles » de petites molécules appelés acides aminés, composés de Carbone ( C ), Hydrogène ( H ), Oxygène ( O ) et Azote ( N ). Il existe environ 20 sortes d’aminoacides différents, si bien qu’il y a une quasi infinité d’arrangements possibles de ces acides aminés, selon l’ordre dans lequel ils sont placés, selon leur nombre, selon les proportions entre les sortes (voir Fig. 4).
 Chaque figure représente un acide aminé, le trait représente la liaison.Un enchaînement d’aminoacides est un polypeptide.
Chaque figure représente un acide aminé, le trait représente la liaison.Un enchaînement d’aminoacides est un polypeptide.
Cette chaine polypeptidique, composée le plus souvent d’un grand nombre de motifs, reste rarement linéaire. Le plus souvent elle s’entortille pour former une sorte de pelote. Elle acquiert ainsi une structure spatiale ou tridimensionnelle qui joue un rôle capital dans sa fonction. Il arrive aussi que plusieurs pelotes s’associent pour constituer la protéine fonctionnelle. Chez les microorganismes, on recense quelques milliers de sortes de protéines différentes, pour passer à un ordre de grandeur du million chez les animaux supérieurs. Les protéines jouent des rôles divers et essentiels pour la cellule, relevant principalement de deux sortes :
- Un rôle de structure, comme les protéines qui entrent dans la composition des membranes, et de divers organites cellulaires ;
- Un rôle catalytique, ce sont les enzymes qui rendent possibles, c’est-à-dire à vitesse suffisante dans les conditions de température ordinaires, les réactions chimiques innombrables accomplies au sein de la cellule. Dans tous les cas la structure spatiale de la protéine conditionne son activité : que cette structure vienne à être modifiée, qu’elle qu’en puisse être la cause (externe ou interne), et la fonction est altérée, voire abolie. La protéine a tous les attributs d’une machine très perfectionnée, une véritable micromachine. Le rêve de Descartes se trouve ainsi réalisé, trois siècles plus tard tandis que son « animal-machine » trop rudimentaire n’avait guère pu convaincre.
La structure tridimensionnelle explique les possibilités de fixation sur une protéine d’un substrat quelconque, en général une molécule de petite taille : le site de fixation possède une forme appropriée permettant l’arrimage du substrat. Dans le cas des enzymes, la fixation de la molécule sur le site dit enzymatique est le prélude à l’action catalytique. Appliquée à la β-G-ase, cette procédure conduit à la fixation du lactose sur l’enzyme qui permet l’action de la molécule d’eau H2O pour casser la liaison et séparer le galactose du fructose. La place est alors libre pour qu’une nouvelle molécule de lactose puisse se positionner : c’est la vocation du catalyseur que d’être recyclé pour resservir.
Un fait attire l’attention de Jacques Monod : la β-G-ase n’est pas présente dans la cellule bactérienne tant qu’on ne l’a pas nourrie de lactose. Elle apparaît, avec un certain délai, une fois le lactose ajouté au milieu. Ce qui suggère que le milieu influence le fonctionnement de la bactérie. Mais comment cette influence opère-t-elle ? Ce problème occupera Jacques Monod plusieurs années, sur fond de controverses scientifiques et de débats idéologiques.
Références
Patrice Debré, Jacques Monod, Flammarion, 1996.
Dominique Lecourt (Dir.), Dictionnaire d’histoire et de philosophie des sciences, PUF, 1999.